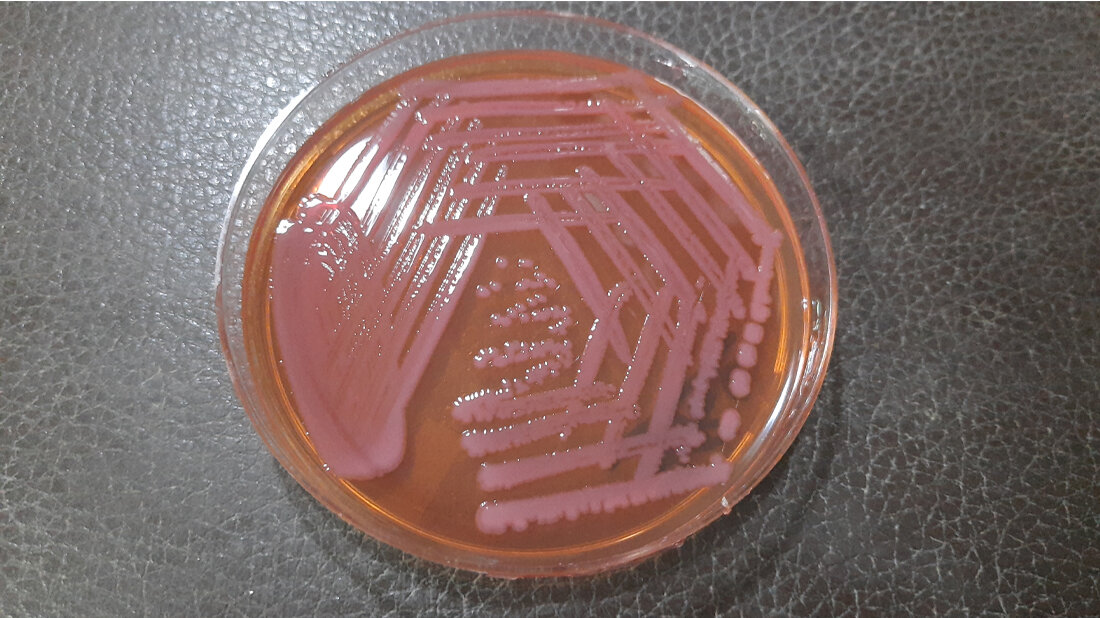
Acitenobacter_baumanii_Agar.jpg Acinetobacter baumannii

Achillesferse von Acinetobacter baumannii entdeckt
Antibiotikaresistenzen sind ein weltweit wachsendes Problem. Geschätzt wird, dass jährlich allein in Europa mehr als 670.000 Menschen an Erregern erkranken, die resistent gegen Antibiotika sind, und geschätzt 33.000 sterben an den von ihnen verursachten Krankheiten. 2017 nannte die WHO Antibiotikaresistenzen als eine der größten Bedrohungen für die Weltgesundheit. Besonders gefürchtet werden Keime, die gleich gegen mehrere Antibiotika resistent sind. Unter ihnen sticht Acinetobacter baumannii hervor, ein Bakterium, dass eine außergewöhnlich hohe Fähigkeit besitzt, Multiresistenzen zu entwickeln und als „Krankenhauskeim“ besonders Patienten mit einem geschwächten Immunsystem bedroht.
Acinetobacter baumannii verhindert das Austrocknen
Acinetobacter baumannii ist sehr widerstandsfähig, da es auch in trockener Umgebung lange infektiös bleiben und so auf den Tastaturen medizinischer Geräte, Stationstelefonen oder Lampen überdauern kann. Diese Eigenschaft hilft der Mikrobe auch dabei, auf der trockenen menschlichen Haut zu überleben oder in Körperflüssigkeiten wie Blut und Urin, die verhältnismäßig hohe Konzentrationen an Salzen und anderen gelösten Stoffen enthalten.
Einen zentralen Mechanismus, mit dem sich Acinetobacter baumannii in solch widriger Umgebung einrichtet, hat jetzt das Wissenschaftsteam der DFG-Forschergruppe 2251 unter Federführung der Goethe-Universität aufgeklärt: Wie viele Bakterien und auch Pflanzen oder Pilze ist Acinetobacter baumannii in der Lage, den Zuckeralkohol Mannitol herzustellen, einen Stoff, der sehr stark Wasser bindet. Dadurch verhindert Acinetobacter baumannii ein Austrocknen.
Einzigartige Herstellung von Mannitol
Fast einzigartig ist jedoch die Art, wie Acinetobacter baumannii Mannitol herstellt: Die beiden letzten Schritte der Mannitol-Herstellung werden durch einen statt wie bei den weitaus meisten Organismen zwei Enzymkomplexe katalysiert. Dieses Enzym „MtlD“ mit zwei katalytischen Aktivitäten entdeckten bereits 2018 Wissenschaftler/-innen um Prof. Beate Averhoff und Prof. Volker Müller. Jetzt ist dem Team von Prof. Klaas Martinus Pos, der ebenfalls Mitglied in der DFG-Forschergruppe ist, gelungen, die räumliche Struktur des Enzyms aufzuklären.
Prof. Pos erklärt: „Wir haben herausgefunden, dass das Enzym gewöhnlicherweise in Form von freien Monomeren vorliegt. Die besitzen zwar die beiden nötigen katalytischen Aktivitäten, sind aber inaktiv. Erst eine trockene oder salzhaltige Umgebung löst den sogenannten osmotischen Stress im Bakterium aus, in dessen Folge sich die Monomere zu Dimeren zusammenlagern. Dann erst wird das Enzym aktiv und produziert Mannitol.“ Außerdem fanden die Wissenschaftler/-innen heraus, welche Stellen in der Struktur besonders wichtig für die katalytischen Funktionen des Enzyms und die Dimer-Bildung sind.
Prof. Volker Müller, Sprecher der DFG-Forschergruppe 2251, ist überzeugt: „Diese Arbeit zeigt einen wichtigen neuen Ansatzpunkt zur Bekämpfung dieses Krankenhauskeims. Denn wir haben eine biochemisch empfindliche Stelle im Stoffwechsel des Krankenhauskeims identifiziert. Hier könnten in der Zukunft maßgeschneiderte Substanzen zur Hemmung des Enzyms ansetzen.“
Quelle: idw/Goethe-Universität Frankfurt am Main
Artikel teilen